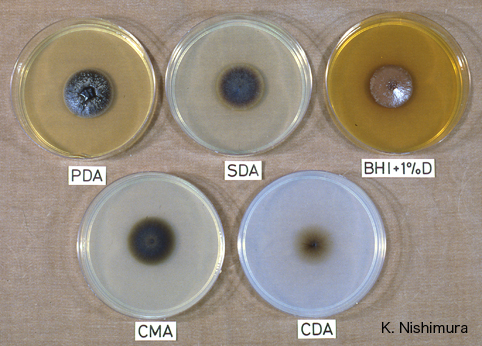

Medication
Treatment. As the underlying cause of ischemic colitis is hypoperfusion of the colon, it is important to remove any potential exacerbating factors and to optimize perfusion of the ischemic region. This entails use of intravenous (IV) fluid resuscitation, optimizing cardiac output, and use of supplemental oxygen.
Procedures
There is no role for steroids in the treatment of ischemic colitis as they only serve in masking the development of peritoneal signs and may delay necessary surgical intervention.36Close monitoring should continue assessing for fever, increasing leukocytosis, development of acidosis, increased abdominal pain or tenderness.
Therapy
Diagnosis. In many cases, endoscopic biopsy may be instrumental in differentiating ischemic colitis from ulcerative or infectious colitis. 36 The combination of history, physical examination findings, laboratory data, radiographic imaging, endoscopy, and biopsy allow for the accurate diagnosis.
Self-care
If you have ischemic colitis and have pain on your right side or sudden belly pain that’s so severe you can’t find a comfortable position, head to the ER or call 911. The artery feeding the right side of your colon also feeds part of the small intestine.
Nutrition
What are the treatment options for ischemic colitis?
What is the role of steroids in the treatment of ischemic colitis?
How is the diagnosis of ischemic colitis made?
When to go to the ER for ischemic colitis pain?

How long does it take to recover from ischemic colitis?
Prognosis for Ischemic Colitis Nearly all people with ischemic colitis improve and recover over a period of 1 to 2 weeks. However, when the interruption to the blood supply is more severe or more prolonged, the affected portion of the large intestine may have to be surgically removed.
Does ischemic colitis require surgery?
Severe ischemic colitis that does not respond to other treatments may require surgery. An estimated 20% of people with the condition will need some form of surgical intervention. Those with underlying medical conditions are more likely to need surgery.
Can ischemic colitis be reversed?
Ischemic Colitis Treatment It usually heals on its own, but you may get antibiotics to prevent infection.
What is the difference between colitis and ischemic colitis?
4 “Colitis” is a term that refers to inflammation in the colon, which can be caused by a variety of diseases and conditions. 5 Ischemic colitis is, however, associated with heart disease,2 and maintaining a healthy lifestyle through diet and exercise is important to reducing the risk.
What is the most common cause of ischemic colitis?
The precise cause of diminished blood flow to the colon isn't always clear. But several factors can increase your risk of ischemic colitis: Buildup of fatty deposits on the walls of an artery (atherosclerosis) Low blood pressure (hypotension) associated with dehydration, heart failure, surgery, trauma or shock.
How does ischemic colitis happen?
What causes ischemic colitis? IC occurs when there's a lack of blood flow to your colon. The hardening of one or more of the mesenteric arteries may cause a sudden reduction in blood flow, which is also called an infarction. These are the arteries that supply blood to your intestines.
What foods should I avoid with ischemic colitis?
Watch out for items that can be troublemakers if you have UC, including:Alcohol.Caffeine.Carbonated drinks.Dairy products, if you're lactose intolerant.Dried beans, peas, and legumes.Dried fruits.Foods that have sulfur or sulfate.Foods high in fiber.More items...•
When do you repeat colonoscopy after ischemic colitis?
Repeat colonoscopy after 24 hours showed mucosal oedema, irregular ulcerations and submucosal haemorrhages in the region of descending colon and splenic flexure [Table/Fig-1, 2]. The biopsy showed oedematous lamina propria with haemorrhages and congested capillaries suggestive of acute ischaemic changes [Table/Fig-3].
Can you survive ischemic bowel?
This results in the contents of the intestine leaking into the abdominal cavity, causing a serious infection (peritonitis). Scarring or narrowing of your colon. Sometimes the intestines can recover from ischemia, but as part of the healing process the body forms scar tissue that narrows or blocks the intestines.
Is ischemic colitis cancerous?
Approximately 5% of patients with ischemic colitis have an obstructing lesion, usually in the distal colon. Half of these patients have colon cancer while the remainder have strictures caused by disorders such as diverticulitis, radiation and previous surgery.
What to do if you have ischemic colitis and have pain on your right side?
The artery feeding the right side of your colon also feeds part of the small intestine. A blockage there can quickly damage or kill tissue.
What test is done to check for ischemic colitis?
Colonoscopy. This test looks inside your colon. The doctor also may take tissue samples to confirm a diagnosis. Ischemic Colitis Treatment. If you have a mild case -- and most cases are mild -- the inner lining of your colon is inflamed, sore, and bleeding.
Why does ischemia cause a lack of blood flow?
It results from a lack of blood flow to the area, usually because an artery is blocked or narrowed. You need blood flow to your colon because it brings oxygen that keeps your tissues alive. If the blockage goes on for too long, it can cause serious problems.
What is the diagnosis of ischemia?
Ischemic Colitis Diagnosis. Ischemic colitis is a master of disguise. Its symptoms can mimic other conditions, including a flare of ulcerative colitis or Crohn’s disease. Those long-lasting conditions result from a problem with your immune system, not low blood flow.
Can a marathon cause ischemic colitis?
Dehydration could play a role, too. It’s rare, but some medications can trigger an ischemic colitis attack. These include:
Can you have another colonoscopy after ischemic colitis?
After your treatment, you may need another colonoscopy to make sure there are no lasting problems. For most people, an ischemic colitis attack is a one-time thing -- it never happens again. In others, it can become an ongoing problem. You might be able to prevent another episode. To stack the odds in your favor:
Can you eat a low fat diet with ischemic colitis?
Ischemic Colitis Diet. This condition results from a blocked artery. If you have it, you should eat a low-fat diet similar to what people with heart disease eat. Multiple small meals may be a better option, too.
What is the treatment for ischemic colitis?
Treatments include medications such as thrombolytic drugs for blood clots or vasodilators to widen narrow arteries. Typically, follow-up colonoscopies are performed to check for healing and complications. Severe ischemic colitis that does not respond to other treatments may require surgery. An estimated 20 percent.
What is ischemic colitis?
Ischemic colitis occurs when there is not enough blood flowing to the colon, also known as the large intestine. It is more likely to occur in people who are over 60, smoke cigarettes, or have diabetes. hospital admissions. Symptoms of ischemic colitis include pain, tenderness, and digestive problems.
What is the most serious complication of ischemic colitis?
The most serious complication of ischemic colitis is gangrene (tissue death). Gangrene results from a loss of blood flow to the tissue and can be life-threatening. People who experience gangrene need surgery to remove the blockage and damaged tissue.
What side of the stomach does ischemic colitis pain occur?
Typically, pain occurs on the left side of the abdomen. Some people may notice blood in their stool, but excessive bleeding suggests another condition, such as Crohn’s disease or cancer. Other symptoms of ischemic colitis include: stomach pain after meals. tenderness in the stomach.
What tests are used to diagnose ischemic colitis?
Imaging tests used to diagnose ischemic colitis include: Ultrasound or abdominal CT scan. Both ultrasound and CT scans allow doctors to see images of the colon and intestines.
Why do people get ischemic coiltis?
People over the age of 60 are most at risk of ischemic coiltis, as their arteries harden with age. Certain factors increase a person’s chance of developing ischemic colitis. These include: Age. Adults over the age of 60 are most at risk, possibly because arteries tend to harden with age.
What is the most common type of ischemia?
Ischemic colitis is the most common type of gut-based ische mia, accounting for 1 in every 2,000. Trusted Source. hospital admissions. Symptoms of ischemic colitis include pain, tenderness, and digestive problems. It is often mistaken for irritable bowel disease (IBD) or other gastrointestinal issues. The condition can develop over time (chronic) ...
How long does it take for ischemic colitis to go away?
Ischemic colitis usually gets better on its own within two to three days. In more-severe cases, complications can include: Tissue death (gangrene) resulting from diminished blood flow. Hole formation (perforation) in your intestine or persistent bleeding. Bowel obstruction (ischemic stricture)
What is ischemia in the colon?
Overview. Ischemic colitis occurs when blood flow to part of the large intestine is reduced. The condition can affect any part of the colon but is most common in the upper left segment. Ischemic colitis occurs when blood flow to part of the large intestine (colon) is temporarily reduced, usually due to constriction of the blood vessels supplying ...
Why does ischemia occur in the colon?
Ischemic colitis occurs when blood flow to part of the large intestine (colon) is temporarily reduced, usually due to constriction of the blood vessels supplying the colon or lower flow of blood through the vessels due to low pressures. The diminished blood flow doesn't provide enough oxygen for the cells in your digestive system, ...
How do you know if you have ischemic colitis?
Symptoms. Signs and symptoms of ischemic colitis can include: Pain, tenderness or cramping in your belly, which can occur suddenly or gradually. Bright red or maroon blood in your stool or, at times, passage of blood alone without stool. A feeling of urgency to move your bowels. Diarrhea.
What medications can cause ischemic colitis?
These medications include: Some heart and migraine medications. Hormone medications, such as estrogen. Antibiotics. Pseudoephedrine. Opioids. Certain medications for irritable bowel syndrome. Chemotherapy medications.
Is ischemia more common in women?
Ischemic colitis that occurs in a young adult may be a sign of a blood-clotting abnormality or inflammation of the blood vessels (vasculitis). Sex. Ischemic colitis is more common in women. Clotting abnormalities.
Is it important to stay hydrated during ischemic colitis?
Making sure to stay adequately hydrated, especially when doing vigorous outdoor activities, is also important — especially for those living in warm climates . A test for clotting abnormalities may be recommended as well, especially if no other cause for ischemic colitis is apparent. By Mayo Clinic Staff.
What is ischemic colitis?
Ischemic colitis (CI) is a common form of ischemic injury, which evolves as a consequence of decreased arterial blood flow to the colon. In general, CI is attributed to an elderly with multiple comorbidities; however, it may also occur in young or middle-aged individuals.
Is ischemic colitis a comorbid condition?
Ischemic colitis: current diagnosis and treatment. Ischemic colitis (CI) is a common form of ischemic injury, which evolves as a consequence of decreased arterial blood flow to the colon. In general, CI is attributed to an elderly with multiple comorbidities; however, it may also occur in young or middle-aged individuals.
What is the treatment for IC?
Treatment for IC typically includes a round of antibiotics, IV fluids and a liquid diet. After diagnosis, most patients will be prescribed antibiotics to prevent infection, and will likely be encouraged to avoid any medications that reduce blood flow.
What is IC in medicine?
Ischemic colitis (IC) is an inflammation of the large intestine (colon) that is caused by a lack of blood flow to the colon. Ischemia refers to an inadequate blood supply to an organ, in this case the colon. It’s typically broken down into two forms:
What is the difference between ischemia and mesenteric ischemia?
Symptoms are usually short-term and surgery is often not necessary. Mesenteric ischemia: Involves lack of blood to the small intestine.
What is IC in surgery?
Summary: Ischemic colitis (IC) is an inflammation of the large intestine (colon) caused by restricted blood flow to the colon.
What is the term for a lack of blood in the small intestine?
Mesenteric ischemia: Involves lack of blood to the small intestine. Typically characterized by abdominal pain experienced about 2 hours after eating, as well as weight loss, nausea, vomiting and occasional bloody stool.
How long does it take for IC to stop?
In most cases, however, symptoms should cease within two to three days . Summary: IC most often occurs in people over 60 years old, particularly those with underlying conditions like atherosclerosis, low blood pressure, IBS, blood clots or diabetes.
Is colitis a form of ulcerative colitis?
This may be due to decreased blood pressure or a blockage of an artery or vein. This form of colitis is not related to ulcerative, microscopic or C diff. colitis. It’s also less serious than mesenteric ischemia, which involves a lack of blood supply to the small intestine.
There are various causes of colitis and each has different treatments
Amber J. Tresca is a freelance writer and speaker who covers digestive conditions, including IBD. She was diagnosed with ulcerative colitis at age 16.
Home Remedies and Lifestyle
For some of the causes of colitis, part of the treatment plan may include care that can be done at home. Changes to diet might also be used for some conditions, either long-term or for a short period of time.
Over-the-Counter (OTC) Therapies
There aren't many over-the-counter remedies that may be recommended to treat the cause of colitis. Vitamin and mineral supplements might be recommended in some cases.
Prescriptions
There are many prescription medications and therapies used to treat colitis. The treatments used will be different based on the cause of colitis. In most cases, therapies are aimed at treating the underlying cause of the inflammation.
Surgeries and Specialist-Driven Procedures
Surgery may be used to treat colitis that’s caused by IBD. This includes either the partial or the total removal of the colon. Surgery might be used when medications have failed to control the disease or there is a risk of colon cancer.
Summary
The treatments for colitis will depend on the underlying cause. For most types, medication and a change in diet are used. For some types, surgery may be needed.
A Word From Verywell
The reasons for the development of colitis are varied, as are the treatments. The key is to get the cause of colitis diagnosed so that it can be treated early and effectively. One of the most important things to know about the early diagnosis and treatment is that bleeding from the rectum is not normal.
How to treat colitis?
Treatment of colitis depends upon the cause and often is focused on symptom relief, supportive care, and maintaining adequate hydration and pain control. Antibiotics may be prescribed to treat infectious causes of colitis. Some bacterial infections that cause colitis resolve without any antibiotic treatment.
What are the symptoms of colitis?
Symptoms of colitis depend upon the cause and may include. abdominal pain, cramping, diarrhea, with or without blood in the stool (one of the hallmark symptoms of colitis). Associated symptoms depend upon the cause of colitis and may include. fever, chills, fatigue,
What is the name of the inflammation of the colon?
Colitis describes inflammation of the colon (col=colon + itis=inflammation). Examples of causes (types) of colitis include. infection, for example, caused by bacteria like C. difficile, viruses, and parasites; inflammatory bowel disease like Crohn's disease and ulcerative colitis,
What is the definition of colitis?
Colitis definition and facts. Colitis refers to inflammation of the inner lining of the colon. There are numerous causes of colitis including infection, inflammatory bowel disease (Crohn's disease and ulcerative colitis are two types of IBD ), ischemic colitis, allergic reactions, and microscopic colitis. Symptoms of colitis depend upon the cause ...
What is the inflammation of the inner lining of the colon?
Colitis describes inflammation of the inner lining of the colon and can be associated with diarrhea, abdominal pain, bloating, and blood in the stool. This inflammation may be due to a variety of reasons, including the following: An illustration of the colon anatomy.
Why do infants get colitis?
In infants younger than 1 year of age, colitis is often due to allergies to cow or soy milk. Allergic colitis may be seen in breastfed babies, where mothers drink cow's milk and pass that protein into their breast milk.
Can C diff be contracted without antibiotics?
Unfortunately, this infection is becoming more common outside the hospital environment, and people can develop community-acquired C. diff colitis without exposure to antibiotics or a medical facility. Worldwide, the most common parasite infection to cause colitis is Entamoeba histolytica.
What causes gas in ischemic colitis?
1. Alcohol. Alcoholic beverages tend to cause excessive gas in combination with difficult digestion. It is best to avoid alcohol altogether when dealing with ischemic colitis, but it is imperative that you not consume alcohol in excessive amounts when dealing with ischemic colitis. 2.
What can I do to help my colon?
Applesauce contains fiber but also has anti-inflammatory properties that can help soothe the colon and make things a little easier on you. 7. Try Coconut Water. Coconut water contains many beneficial ingredients, and it may also aid the colon if you are suffering from ischemic colitis.
How to get rid of a swollen stomach?
In general, many of us are conditioned to eat three meals a day: breakfast, lunch, and dinner. Breaking your meals up into smaller but more frequent ones allows additional time for your stomach to absorb and digest the food.
Is it good to drink water with ischemic colitis?
Drinking plenty of fluids is great advice for you on a regular basis, but it can also be a very good idea if you are suffering from ischemic colitis. Drinking plenty of water can keep the digestive system flowing as well as get rid of waste through urine. As diarrhea is a frequent symptom of ischemic colitis, drinking plenty of water can help with the possible dehydration you may suffer as a result of diarrhea.
Does watermelon help with ischemic colitis?
Because of this, watermelon can not only help while you are suffering from ischemic colitis, but also can help prevent it as well.
Is it better to eat meat or fish with ischemic colitis?
However, a lot of meat proteins are harder for the body to digest, especially when you are suffering from ischemic colitis. Try proteins like tofu and white fish, which can give you that protein value but are much easier for your system to digest and less pressure on your colon.
Can yogurt help with ischemic colitis?
That being said, some dairy products, such as the aforementioned butter milk and probiotics-based yogurt, could actually help the situation. The best advice is to steer clear of dairy if you have had any prior problems with lactose.
Overview
Symptoms
Causes
Risk Factors
Specialist to consult
Complications
Prevention
- Treatment for ischemic colitis depends on the severity of your condition. Signs and symptoms often diminish in two to three days in mild cases. Your doctor may recommend: 1. Antibiotics, to prevent infections 2. Intravenous fluids, if you are dehydrated 3. Treatment for any underlying medical condition, such as congestive heart failure or an irregu...